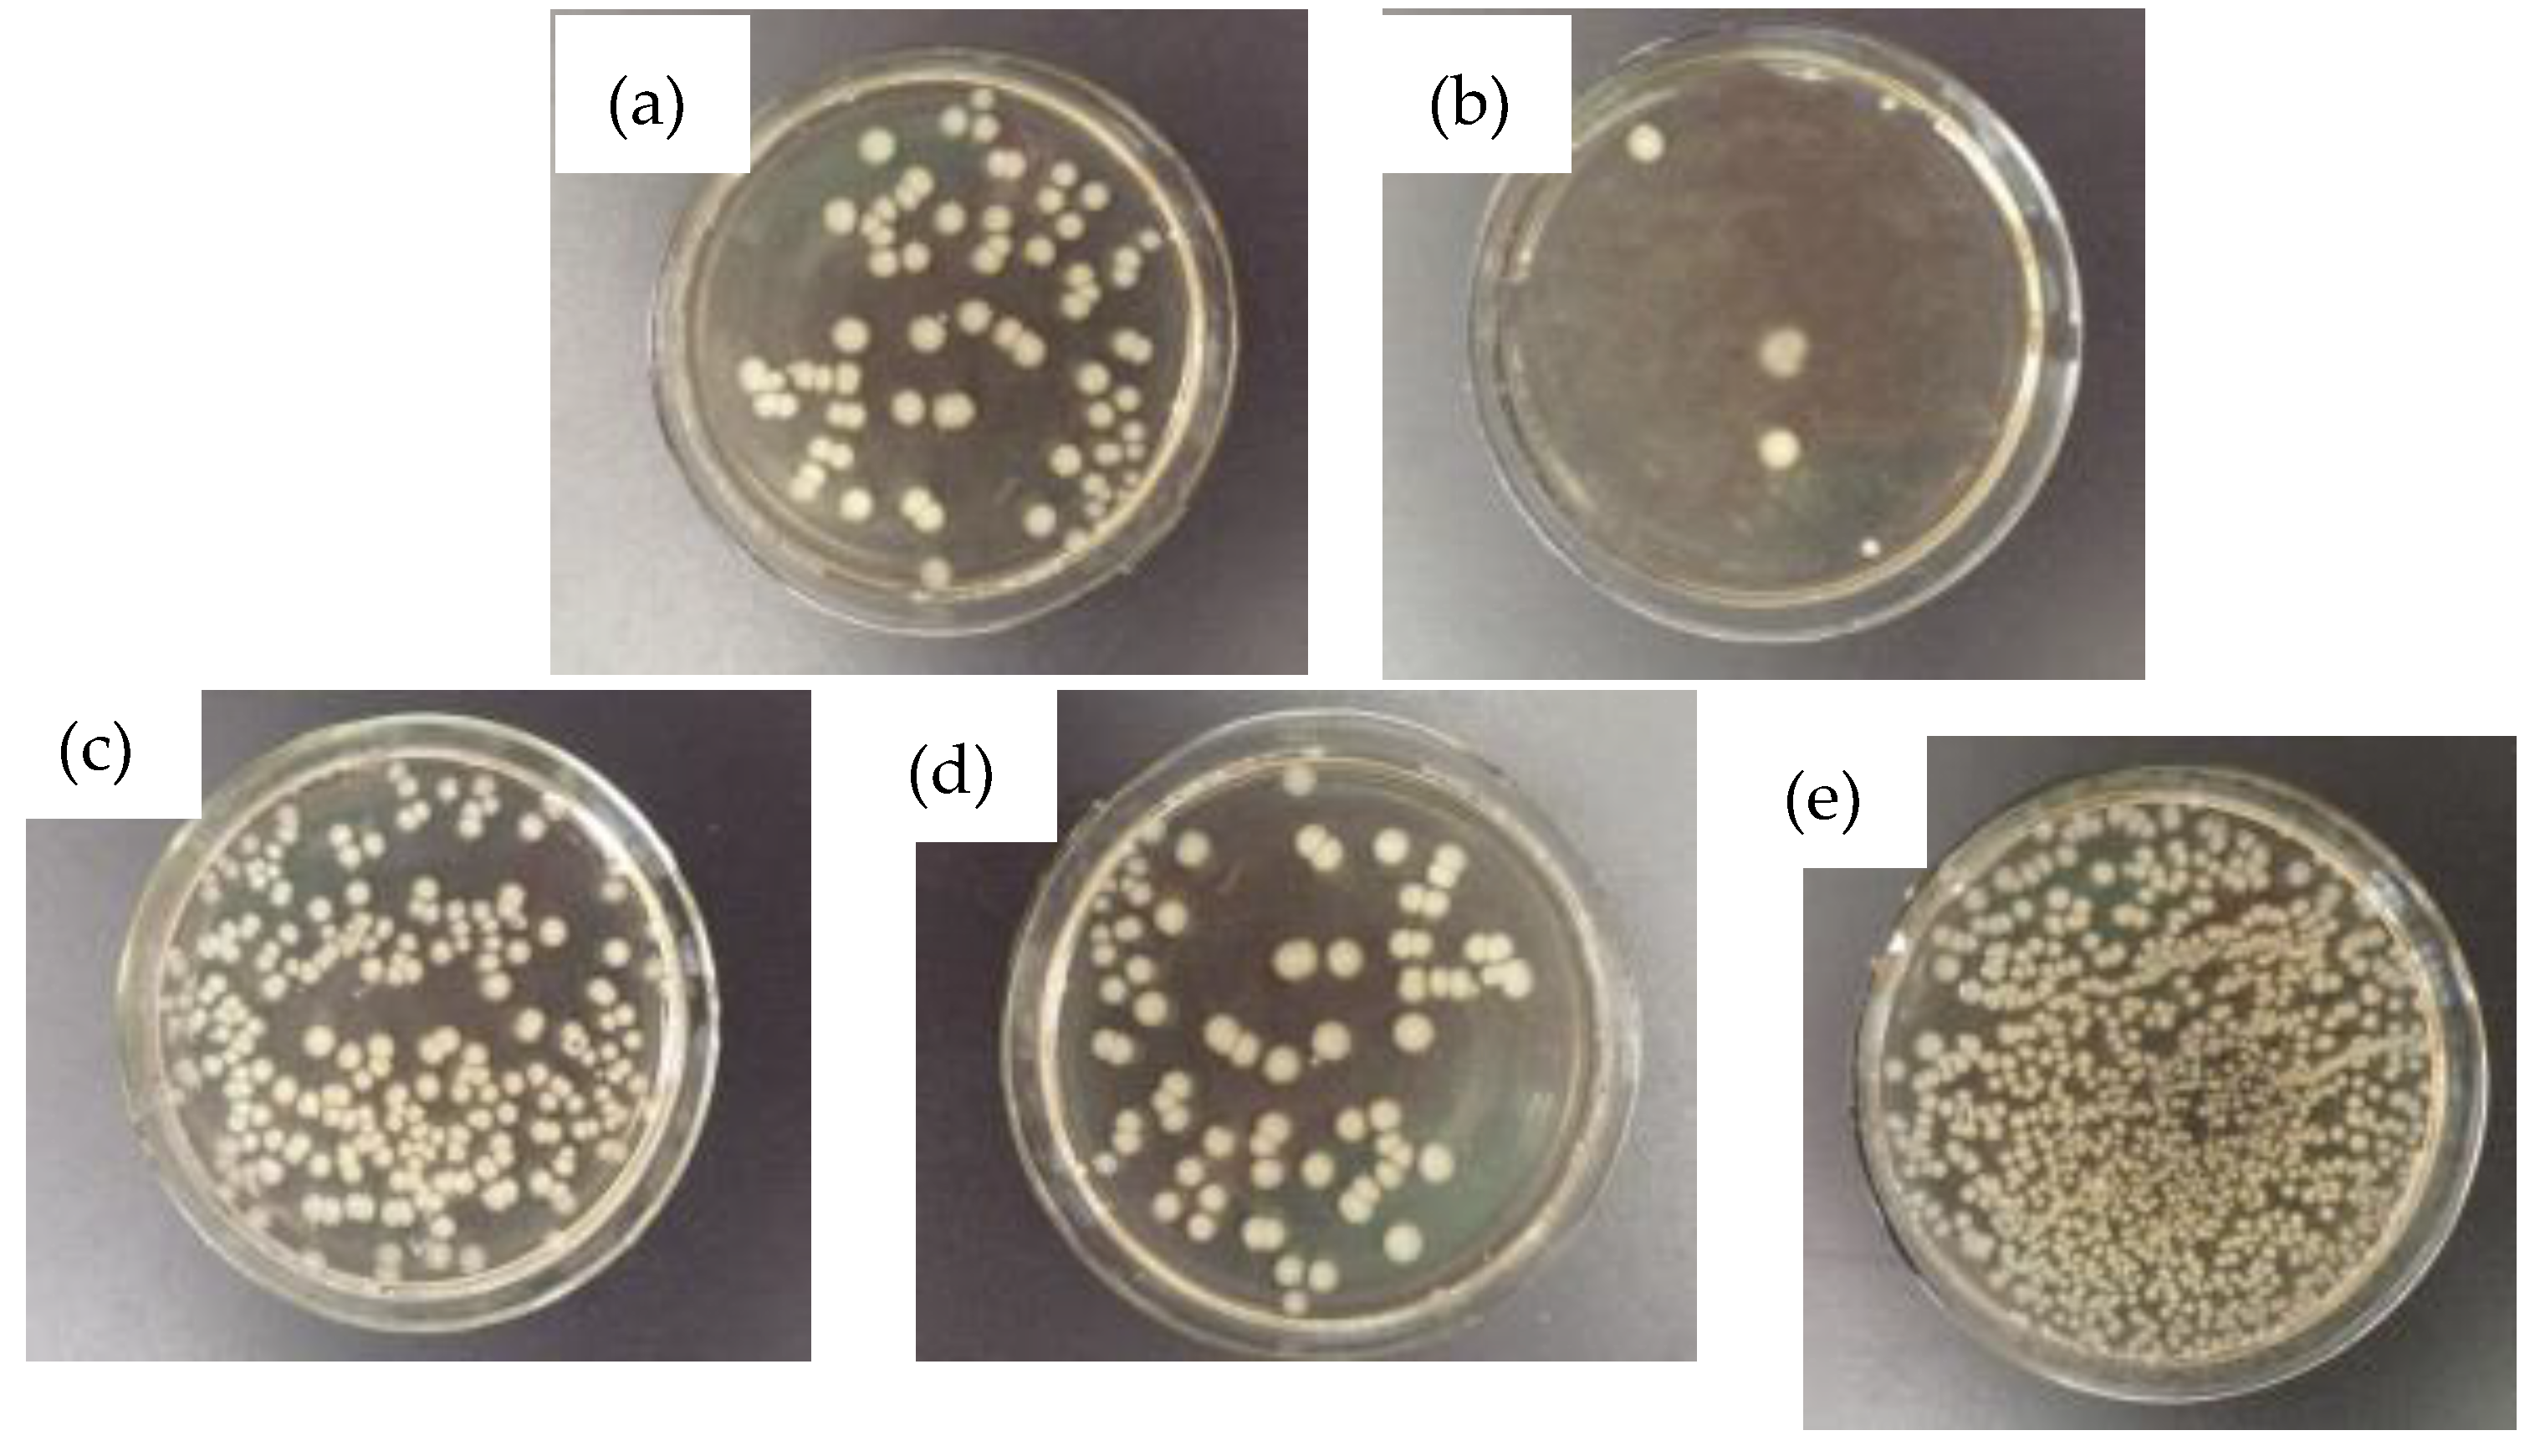
Materials 12 02085 g010 550

Effect of Aging Temperature on the Microstructure and Properties of Economical Duplex Stainless Steel
Abstract
:1. Introduction
2. Materials and Methods
3. Results and Discussion
3.1. Effect of Aging Temperature on the Microstructure
3.2. Effect of Aging Temperature on the Mechanical Properties
3.3. Effect of Aging Temperature on the Pitting Corrosion Resistance
3.4. Effect of Aging Temperature on Antibacterial Properties
4. Conclusions
- After aging NSSC 2120 stainless steel samples at various temperatures in the range 650–950 °C, γ and α phases were observed in its structure. In addition to these two phases, a ε-Cu phase was precipitated in SX-750, while CrMn1.5O4 and MnS phases were precipitated in SX-850.
- The antibacterial rate of SX-750 was 98.8% due to the precipitation of the face-centered cubic structure of the ε-copper phase in the sample after aging at 750 °C, while simultaneously worsening the pitting resistance and decreasing the tensile strength of the material.
- The oxides containing Mn and Cr (CrMn1.5O4) and sulfides (MnS) precipitated from the specimens after aging at 850 °C, the corrosion damage degree to the specimens was greater than that of the ε-Cu phase and the tensile strength of the specimens decreased to the lowest value; hence, the specimens did not exhibit an antimicrobial effect.
Author Contributions
Funding
Conflicts of Interest
References
- Tang, Y.; Dai, N.; Wu, J.; Jiang, Y.; Li, J. Effect of surface roughness on pitting corrosion of 2205 duplex stainless steel investigated by electrochemical noise measurements. Materials 2019, 12, 738. [Google Scholar] [CrossRef] [PubMed]
- Guo, Y.; Hu, J.; Li, J.; Jiang, L.; Liu, T.; Liu, Z.; Wu, Y. Effect of annealing temperature on the mechanical and corrosion behavior of a newly developed novel lean duplex stainless steel. Materials 2014, 7, 6604–6619. [Google Scholar] [CrossRef] [PubMed]
- Iza-mendia, A.; Piñol-Juez, A.; UrcolaI, J.J.; Gutiérrez, I. Microstructural and mechanical behavior of a duplex stainless steel under hot working conditions. Metall. Mater. Trans. A 1998, 29, 2975–2986. [Google Scholar] [CrossRef]
- Hutchinson, W.H.; Ushioda, K.; Ruunsj, G. Anisotropy of tensile behavior in a duplex stainless steel sheet. Mater. Sci. Technol. 1985, 1, 728–731. [Google Scholar] [CrossRef]
- Xu, T.; Fang, X.Y.; Zhu, Y.L.; Wang, M.; Yin, W.H.; Guo, H. Grain orientation and interface character distribution during austenite precipitation phase in duplex stainless steel. J. Mater. Eng. 2018, 46, 34–40. [Google Scholar]
- Ihsan-ul-Haq, T.; Jung, H.P.; Sang, K.H. Development of high Mn-N duplex stainless steel for automobile structural components. Corros. Sci. 2008, 50, 404–410. [Google Scholar]
- Iacovielloa, F.; Casarib, F.; Gialanellab, S. Effect of “475 °C embrittlement” on duplex stainless steels localized corrosion resistance. Corros. Sci. 2005, 47, 909–922. [Google Scholar] [CrossRef]
- Wu, J. Duplex Stainless Steel, 1st ed.; Metallurgical Industry Press: Beijing, China, 1999; pp. 1–18. [Google Scholar]
- Chen, T.H.; Weng, K.L.; Yang, J.R. The effect of high-temperature exposure on the microstructural stability and toughness property in a 2205 duplex stainless steel. Mater. Sci. Eng. A 2002, 338, 259–270. [Google Scholar] [CrossRef]
- Xie, Y. Research on the Precipitated Phase of 25Cr5NiMoN Duplex Stainless Steel. Master’s Thesis, Harbin Engineering University, Harbin, China, 2011. [Google Scholar]
- Josefsson, B.; Nilsson, J.O.; Wilson, A. Phase transformations in duplex steels and relation between continuous cooling and isothermal heat treatment. Duplex Stainl. Steels’91 1991, 1, 67–78. [Google Scholar]
- Straffelini, G.; Baldo, S.; Calliari, I.; Ramous, E. Effect of aging on the fracture behavior of the lean duplex stainless steel. Metall. Mater. Trans. A 2009, 40, 2616–2621. [Google Scholar] [CrossRef]
- Zhang, L.H.; Jiang, Y.M.; Zhang, W.; Xu, J.; Li, J. Effect of aging on the corrosion resistance of 2101 lean duplex stainless steel. Mater. Charact. 2009, 60, 1522–1528. [Google Scholar] [CrossRef]
- Guo, L.F.; Li, X.J.; Sun, T.; Xu, J.; Li, J.; Jiang, Y. The influence of sensitive temperature on the localized corrosion resistance of duplex stainless steel SAF2304. Acta Metall. Sin. 2012, 48, 1503–1509. [Google Scholar] [CrossRef]
- Zhang, W.; Jiang, L.Z.; Hu, J.C.; Song, H. Study of mechanical and corrosion properties of a Fe-21.4Cr-6Mn-1.5Ni-0.24N-0.6Mo duplex stainless steel. Mater. Sci. Eng. A 2008, 497, 501–504. [Google Scholar]
- Sieurin, H.; Sandstrom, R.; Westin, E.M. Fracture toughness of the lean duplex stainless steel LDX 2101. Metall. Mater. Trans. A 2006, 37, 2975–2981. [Google Scholar] [CrossRef]
- Chuang, Y.; Schnid, R.; Chang, Y.A. Thermodynamic analysis of the iron-copper system I: The stable and metastable phase equilibria. Metall. Mater. Trans. A 1984, 15, 1921–1930. [Google Scholar] [CrossRef]
- Ren, Y.B.; Yang, K.; Zhang, B.C.; Liang, Y. An Ultra Pure High Nitrogen Austenitic Stainless Steel and Its Preparation Method. Chinese Patent 02132853.6, 3 September 2002. [Google Scholar]
- Qiu, S.Q.; Zhu, G.H. The Principle and Process of Electric Furnace Steelmaking, 1st ed.; Metallurgical Metallurgical Industry Press: Beijing, China, 1996; pp. 110–130. [Google Scholar]
- Lai, H.Y.; Liu, G.X. The Alloy Diffusion and Thermodynamics, 1st ed.; Metallurgical Industry Press: Beijing, China, 1984; pp. 5–23. [Google Scholar]
- Xu, L.F.; Mao, W.M.; Meng, L. Aging behavior of 50W540 non-oriented silicon steel. Heat Treat. Met. 2009, 34, 42–45. [Google Scholar]
- Ren, Y. Reasearch on Magnetic Aging Behavior and Its Influencing Factors of Non-Oriented Electrical Steel. Master’s Thesis, University of Science and Technology Beijing, Beijing, China, 2013. [Google Scholar]
- Osamura, K.; Okuda, H.; Asano, K.; Furusaka, M.; Kishida, K.; Kurosawa, F.; Uemori, R. SANS study of phase decomposition in Fe-Cu alloy with Ni and Mn addition. ISIJ Int. 1994, 34, 346–354. [Google Scholar] [CrossRef]
- Oikawa, K.; Ishida, K.; Nishizawa, T. Effect of titanium addition on the formation and distribution of MnS inclusions in steel during solidification. ISIJ Int. 1997, 37, 332–338. [Google Scholar] [CrossRef]
- Zhang, Z.X. Microstructures and Preoterties of Copper (Nitrogen)-Bearing Antibacterial Stainless Steels. Ph.D. Thesis, Shanghai Jiao Tong University, Shanghai, China, 2009. [Google Scholar]
- Zhou, H.J.; Huang, M.Z. Strength of Metal Materials, 1st ed.; Science Press: Beijing, China, 1989; pp. 124–162. [Google Scholar]
- He, Z.J. Mechanical Properties of Metal, 1st ed.; Metallurgical Industry Press: Beijing, China, 1982; pp. 90–115. [Google Scholar]
- Wang, F.P.; Kang, W.L.; Jing, H.P. Principles, Methods and Applications of Corrosion Electrochemistry, 1st ed.; Chemical Industry Press: Beijing, China, 2008; pp. 145–165. [Google Scholar]
- Xiang, H.L.; Fan, J.C.; Liu, D.; Gu, X. Effects of antibacterial aging treatment on microstructure and properties of copper-containing duplex stainless steel II. Corrosion resistance and antibacterial properties. Acta Metall. Sin. 2012, 48, 1089–1096. [Google Scholar] [CrossRef]
- Liu, Y.Q.; Nan, L.; Chen, M.; Yang, K. Study of a Cu-containing martensitic antibacterial stainless steel. Rare Met. Mater. Eng. 2008, 37, 1380–1383. [Google Scholar]
- Zhao, W.F.; Shu, J.; Bi, H.Y. Effect of copper on the mechanical property and corrosion behavior of 19Cr-1.6Mo ferritic stainless steel. J. Iron Steel Res. 2012, 24, 45–50. [Google Scholar]
- Webb, E.G.; Alkire, R.C. Pit initiation at sigle sulfide inclusions in stainless steel I. Electrochemical microcell measurements. J. Electrochem. Soc. 2002, 149, B272–B279. [Google Scholar] [CrossRef]
- Lv, M.Q.; Chen, S.H.; Dong, J.S.; Yang, K. Antibacterial properties of Cu-containing ferrite stainless steel. Chin. J. Mater. Res. 2005, 19, 581–588. [Google Scholar]
- Yin, H.X. Copper Precipitation Mechanism and Performance Control of Ferritic Antibacterial Stainless Steel. Ph.D. Thesis, University of Science and Technology Beijing, Beijing, China, 2015. [Google Scholar]
- Bahmani-Oskooee, M.; Nedjad, S.H.; Samadi, A.; Kozeschnik, E. Cu-bearing, martensitic stainless steels for applications in biological environments. Mater. Des. 2017, 130, 442–451. [Google Scholar] [CrossRef]
- Chen, S.H.; Lv, M.Q.; Zhang, J.D.; Dong, J.S.; Yang, K. Microstructure and antibacterial properties of Cu-Contained antibacterial stainless steel. Acta Metall. Sin. 2004, 40, 314–318. [Google Scholar]
- Lin, G.; Shen, J.C.; Wang, R.M. Study on synthesis and magnetic propertie of NiCuZn ferrite. J. Funct. Mater. 2011, 42, 549–551. [Google Scholar]

| Element | C | Si | Mn | S | P | Cr | Ni | Mo | Cu | N | Fe |
|---|---|---|---|---|---|---|---|---|---|---|---|
| 2120 | 0.007 | 0.100 | 3.269 | 0.007 | 0.014 | 20.942 | 2.265 | 0.435 | 1.322 | 0.182 | Bal. |
| Test Position | O | Ni | Si | Cr | Mn | Fe | Cu | S |
|---|---|---|---|---|---|---|---|---|
| ① | 0 | 0 | 0.27 | 18.8 | 3.33 | 58.57 | 17.99 | 0 |
| ② | 0 | 0 | 0.26 | 21.46 | 3.13 | 67.06 | 7.36 | 0 |
| ③ | 28.53 | 0.01 | 0.12 | 47.56 | 20.78 | 1.82 | 0 | 0 |
| ④ | 0 | 1.03 | 0.24 | 22.28 | 5.36 | 67.53 | 1.32 | 0 |
| ⑤ | 1.07 | 0.01 | 0.48 | 1.05 | 65.46 | 2.72 | 0.14 | 29 |
| Samples | Bacteria Count [cfu·mL−1] | R [wt%] |
|---|---|---|
| SX-650 °C | 8.00 × 104 | 88.8 |
| SX-750 °C | 8.00 × 103 | 98.8 |
| SX-850 °C | 2.19 × 105 | 69.4 |
| SX-950 °C | 8.30 × 104 | 88.4 |
| 2205 | 7.15 × 105 | 0 |
© 2019 by the authors. Licensee MDPI, Basel, Switzerland. This article is an open access article distributed under the terms and conditions of the Creative Commons Attribution (CC BY) license (http://creativecommons.org/licenses/by/4.0/).
Share and Cite
Xiang, H.; Liu, C.; Deng, L.; Zheng, K. Effect of Aging Temperature on the Microstructure and Properties of Economical Duplex Stainless Steel. Materials 2019, 12, 2085. https://doi.org/10.3390/ma12132085
Xiang H, Liu C, Deng L, Zheng K. Effect of Aging Temperature on the Microstructure and Properties of Economical Duplex Stainless Steel. Materials. 2019; 12(13):2085. https://doi.org/10.3390/ma12132085
Chicago/Turabian StyleXiang, Hongliang, Chunyu Liu, Liping Deng, and Kaikui Zheng. 2019. "Effect of Aging Temperature on the Microstructure and Properties of Economical Duplex Stainless Steel" Materials 12, no. 13: 2085. https://doi.org/10.3390/ma12132085
APA StyleXiang, H., Liu, C., Deng, L., & Zheng, K. (2019). Effect of Aging Temperature on the Microstructure and Properties of Economical Duplex Stainless Steel. Materials, 12(13), 2085. https://doi.org/10.3390/ma12132085

